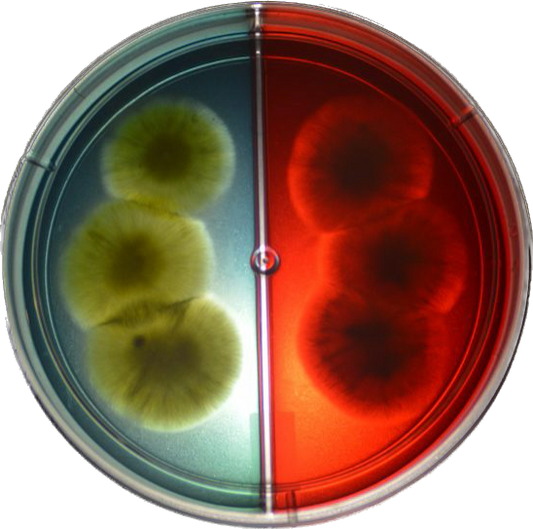

Collection: Products
-
Adrocil 10ml (Keterolac tromethamine)
Regular price €6,95 EURRegular priceUnit price / perSale price €6,95 EUR -
Aleon 10ml (Atropine)
Regular price €7,95 EURRegular priceUnit price / perSale price €7,95 EUR -
Aureodermil 5g (Neomycin + Prednisolone + Sulfacetamide)
Regular price €8,65 EURRegular priceUnit price / perSale price €8,65 EUR -
ChroMyco® Duo Dermatophyte Test System
Regular price €30,00 EURRegular priceUnit price / perSale price €30,00 EUR -
Corticil 5g (Prednisolon)
Regular price €6,15 EURRegular priceUnit price / perSale price €6,15 EUR -
Crotax 5 gram (Chloramphenicol ointment)
Regular price €11,90 EURRegular priceUnit price / perSale price €11,90 EUR -
Crotax 5 ml (Chloramphenicol drops)
Regular price €11,80 EURRegular priceUnit price / perSale price €11,80 EUR -
CS-Pro VET
Regular price €0,00 EURRegular priceUnit price / perSale price €0,00 EUR -
Dorzoglau 5ml (Dorzolamide)
Regular price €7,25 EURRegular priceUnit price / perSale price €7,25 EUR -
EthyCalm® + (Vapocoolant)
Regular price €29,75 EURRegular priceUnit price / perSale price €29,75 EUR -
Hidratop 10 ml (Sodium hyaluronate)
Regular price €9,75 EURRegular priceUnit price / perSale price €9,75 EUR -
Homatrocil 5ml (Dexamethasone)
Regular price €5,95 EURRegular priceUnit price / perSale price €5,95 EUR -
IOP Vet (semi-kwantitatieve oogdrukmeter)
Regular price €90,00 EURRegular priceUnit price / perSale price €90,00 EUR -
Midria 5ml (Cyclopentolate)
Regular price €5,95 EURRegular priceUnit price / perSale price €5,95 EUR -
Nageboorteset (merrie met retentio secundinarum). Inclusief opbergdoos en 2 (steriele) katheters
Regular price €79,50 EURRegular priceUnit price / per€99,50 EURSale price €79,50 EURSale -
Ocil 5g (Oxytetracycline)
Regular price €6,35 EURRegular priceUnit price / perSale price €6,35 EUR